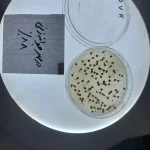
بذر توتون

Semillas de tabaco con la marca AABT propiedad de Atra Atlas Holding
El tabaco es una planta de hojas anchas que originalmente crecía en América del Norte y del Sur y que ahora se cultiva en todo el mundo. El nombre tabaco también se utiliza para referirse a las hojas secas y cortadas de esta planta. El uso principal de esta planta es fumar el humo que se produce al quemar sus hojas secas, que contiene nicotina.
Brasil es el mayor exportador mundial de tabaco desde hace 25 años. Brasil es el segundo mayor productor de tabaco del mundo y el principal exportador desde 1993, gracias a la calidad e integridad del producto, que cumple con los más estrictos estándares internacionales. El país produce más de 700.000 toneladas de tabaco al año.
El tabaco es una planta anual, por lo que es necesario plantar semillas de tabaco todos los años. Se necesitan al menos 7 meses desde la semilla hasta la madurez. Siembre las semillas de tabaco en una bandeja de semillas u otro recipiente aproximadamente 8 semanas antes de la última helada.
Atra Atlas International and Trading Holding es el importador de semillas de tabaco bajo la marca AABT perteneciente a esta empresa a nuestro querido país de Irán.
La marca de tabaco AABT de la empresa tiene una tasa de éxito de germinación del 88,8. Puede ponerse en contacto con Atra Atlas Trading Holding para comprar las mejores semillas de tabaco disponibles en Irán (marca AABT).